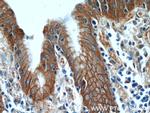
Alpha E catenin Antibody in Immunohistochemistry (Paraffin) (IHC (P))

Search
Proteintech
Alpha E catenin Polyclonal Antibody
{{$productOrderCtrl.translations['antibody.pdp.commerceCard.promotion.promotions']}}
{{$productOrderCtrl.translations['antibody.pdp.commerceCard.promotion.viewpromo']}}
{{$productOrderCtrl.translations['antibody.pdp.commerceCard.promotion.promocode']}}: {{promo.promoCode}} {{promo.promoTitle}} {{promo.promoDescription}}. {{$productOrderCtrl.translations['antibody.pdp.commerceCard.promotion.learnmore']}}
产品信息
12831-1-AP
种属反应
已发表种属
宿主/亚型
分类
类型
抗原
偶联物
形式
浓度
规格
纯化类型
保存液
内含物
保存条件
运输条件
产品详细信息
Immunogen sequence: SEMDNYEPG VYTEKVLEAT KLLSNTVMPR FTEQVEAAVE ALSSDPAQPM DENEFIDASR LVYDGIRDIR KAVLMIRTPE ELDDSDFETE DFDVRSRTSV QTEDDQLIAG QSARAIMAQL PQEQKAKIAE QVASFQEEKS KLDAEVSKWD DSGNDIIVLA KQMCMIMMEM TDFTRGKGPL KNTSDVISAA KKIAEAGSRM DKLGRTIADH CPDSACKQDL LAYLQRIALY CHQLNICSKV KAEVQNLGGE LVVSGVDSAM SLIQAAKNLM NAVVQTVKAS YVASTKYQKS QGMASLNLPA VSWKMKAPEK KPLVKREKQD ETQTKIKRAS QKKHVNPVQA LSEFKAMDSI (188-536 aa encoded by BC031262)
靶标信息
Associates with the cytoplasmic domain of a variety of cadherins. The association of catenins to cadherins produces a complex which is linked to the actin filament network, and which seems to be of primary importance for cadherins cell-adhesion properties. Can associate with both E- and N-cadherins. Originally believed to be a stable component of E-cadherin/catenin adhesion complexes and to mediate the linkage of cadherins to the actin cytoskeleton at adherens junctions. In contrast, cortical actin was found to be much more dynamic than E-cadherin/catenin complexes and CTNNA1 was shown not to bind to F-actin when assembled in the complex suggesting a different linkage between actin and adherence junctions components. The homodimeric form may regulate actin filament assembly and inhibit actin branching by competing with the Arp2/3 complex for binding to actin filaments. May play a crucial role in cell differentiation.
仅用于科研。不用于诊断过程。未经明确授权不得转售。
生物信息学
蛋白别名: 102 kDa cadherin-associated protein; alpha E catenin; Alpha E-catenin; alpha(E)-catenin; alpha-E-catenin; cadherin associated protein; Cadherin-associated protein; CAP102; catenin (cadherin associated protein), alpha 1; catenin (cadherin-associated protein), alpha 1, 102kDa; catenin alpha 1; Catenin alpha-1; catenin, alpha 1; epididymis secretory sperm binding protein; Renal carcinoma antigen NY-REN-13; unnamed protein product
基因别名: 2010010M04Rik; AA517462; AI988031; CAP102; Catna1; CTNNA1; MDBS2; MDPT2
UniProt ID: (Human) P35221, (Mouse) P26231
Entrez Gene ID: (Human) 1495, (Rat) 307505, (Mouse) 12385